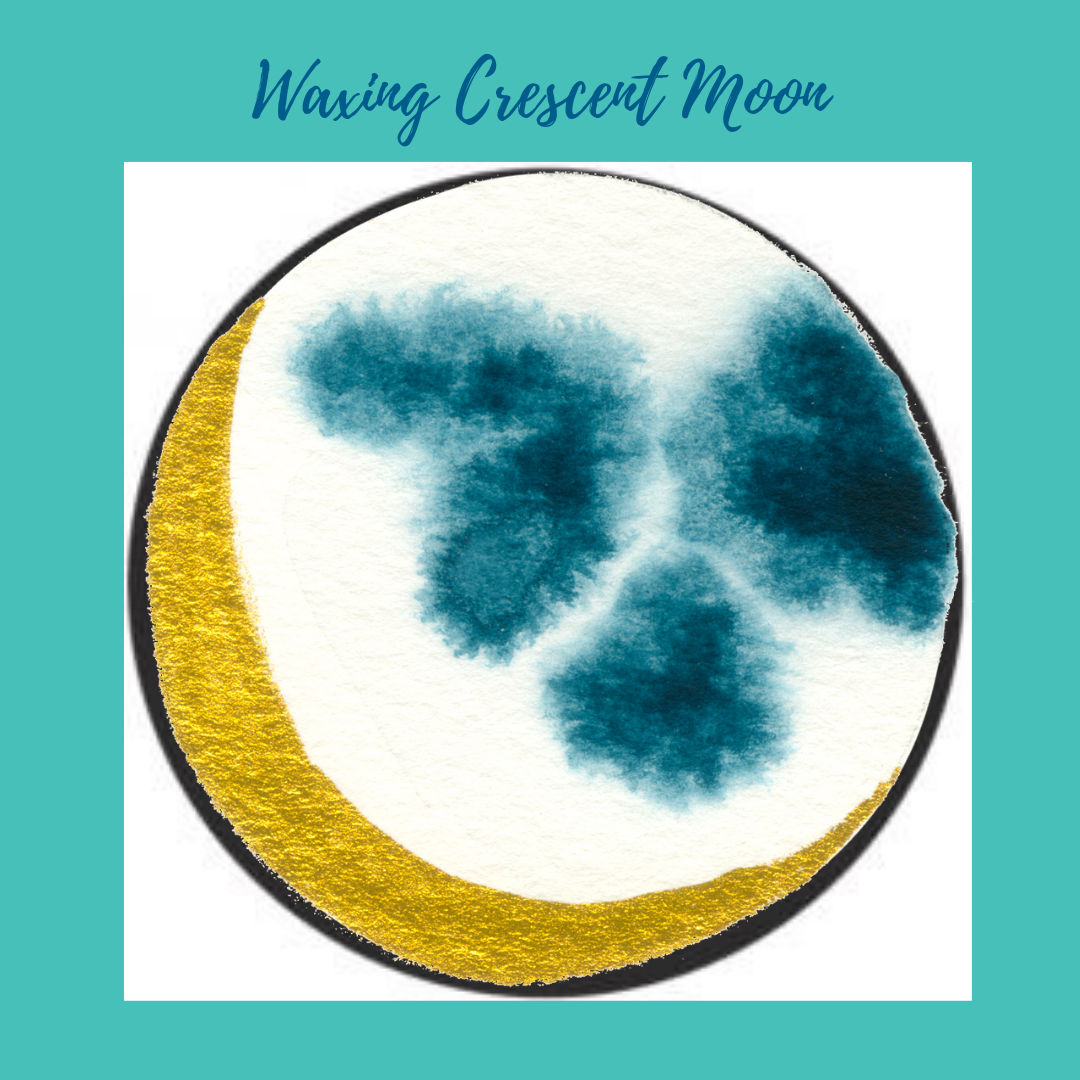

Whilst at first it may seem a little woo-woo, harnessing the energy of them Moon as she moves through her phases is actually something that is very strategic and logical and can make planning- in both your business and your life- much easier!
Gazing at the Moon and using the Moon’s energy has guided humans for eons, and scientific studies have been conducted that show the moon has effects on our mood and energy. We know that the lunar cycle controls the ocean tides, it affects reproduction in fish, melatonin levels in birds, hormonal changes in insects and can also impact on our menstrual cycles.
For centuries farmers have planted crops and harvested at particular times depending on the moon, and just like the moon affects the tides, she can also impact on the salt water that arises within our own bodies which are comprised of 50-70% water. It’s water that stores our emotions and energy and you may have even felt this on a Full Moon with stronger emotions and restless sleep.
Mama Moon may seem mystical and magical but her power is real, and harnessing that is advantageous for us humans here on earth. When you start noticing and tracking the phases from new moon to full moon, as well as how you feel physically, mentally and emotionally at each phase, you will start becoming aware of just how powerful them Moon really is.
Tracking the Moon and using the Moon phases in my own planning and goal setting has had a really positive effect on my lifestyle and how I run my business and I want to share this practice so that you can also learn how to harness the power of the Moon to optimise your energy and abundance.
The Power of the Lunar Cycle
The Moon is Earth’s only satellite and is a quarter the size of Earth, which is a bigger ratio than other planets and their Moons have. The cycle of the Moon is what we reference as the Moon orbits around Earth and as it does so, the Moon appears differently to us, which tells us the age of the Moon’s cycle at each point. The whole cycle takes 29.5 days to complete for us watching it from Earth. What we actually see is what the sun illuminates and we see the light and shadow at different angles as the Moon rotates Earth.
Depending on which phase the Moon is in, our energy levels rise and fall, and our creativity peaks and troughs, meaning there are times that are optimal for planning, starting new projects, writing blog posts, de-cluttering and closing out on projects. When we do those things at the most optimal lunar time, it can help us to be more focussed, energised and successful.
Below you will fine an outline of the 8 phases of the Moon and what tasks are best to during each phase. To then harness this energy in the best way during each Moon phase, use the resources in the free downloadable printable packet which you can get by entering your details below. It includes a lunar calendar, Moon phase reflection and affirmation cards and Moon time manadalas so you can start following the phases and implementing this information right away for your business.
Let’s now look more closely at the Moon cycle and what to expect in each phase.
The complete lunar cycle is made up of 8 distinct Moon phases that are: New Moon, Waxing Crescent, First Quarter, Waxing Gibbous, Full Moon, Waning Gibbous, Last Quarter, and Waning Crescent. The cycle starts at day 1 on the New Moon which is a time of new beginnings and as the Moon gets bigger (waxes) energies shift, increasing in energy over the space of around 14 days until the Full Moon when energies peak. The Moon then becomes smaller (wanes) and energies start to also recede over the space of another 14 days as we approach the New Moon again which is a time of release and closure.
The cycle then starts over- it is very predictable and a constant in our life as much as the sun rising and falling every day- which makes it easy for us to plan what we want to work on depending on the Moon phase we are in.
The New Moon- Fresh Start
During the New Moon, the Moon is not visible in the sky because it’s between the sun and the earth, so the dark side of the moon which doesn’t have light from the sun shining on it is all that we can see (or not see!) and marks the beginning of the waxing cycle and a fresh start in our lives too.
During the New Moon it is a good time to set new goals and gather new insights and ideas for new projects. New creative ideas might spark and it is a good time for brainstorming. It is a wonderful time to connect with other women and you could make a vision board for your business at this time. The New Moon is the ideal time to begin product launches, start sales & marketing campaigns, and begin the production of new workbooks & content.
You might feel lower energy in the New Moon, and you could be quite introspective. This is a good time to practice a grounding meditation and spend time in nature.
The Waxing Crescent Moon- Initiate
Between 3-4 days after the New Moon, a crescent of the Moon will become visible and this is a good time to start putting those New Moon intentions into motion. Just as the Moon is growing, you can start to grow your business and life goals. This is when you should really hold your vision and ideas and start to develop a structure for bringing them into fruition. It’s a good time to update your services, schedule meetings and plant the seeds of your projects.
Take this opportunity to get clear, write down your desires and what you want to accomplish, and visualise yourself working through and achieving your goals. You will probably start to feel your energy levels begin to rise and you will have better focus now too. This phase can also bring with it feelings of frustration and lack of motivation so take inspired action daily.
The First Quarter Moon- Action
Three to four days later the Moon will be halfway visible. This is the perfect time to enthusiastically step towards your goals and to really make progress. As the Moon grows every day, use the same momentum to your advantage to grow your intentions. This action will be easy to do at this stage as you will have much higher energy levels and the Moon will be bringing a desire to get things into order to make them happen.
Bring an awareness to how you are communicating and if you get new ideas write them down but don’t get side-tracked. The energy at this time makes us feel powerful and uplifted and in this halfway period we might feel stuck between wanting to work like crazy and have time to relax. You need to be flexible in putting your plans into action- stay focused on your new moon intentions by writing lists and journaling, and utilise the increased energy to take inspired action.
The Waxing Gibbous Moon- Improve
The final phase of the Moon before it is Full Moon, and this is when you will experience a final burst of momentum, a desire to finalise all the things, and you will begin to notice your plans falling into place. If you need to delegate tasks to complete them before the Full Moon, then do this here in this phase to avoid overwhelm. It is a great time for collaborations and consistent action. Now is a good time to fill in the details and focus on the tasks you need to complete, and you will likely be feeling energised and engaged as you go about your work and take action in a big way.
It’s important in this phase that you move your body as the energy intensifies and peaks. This will help to keep you grounded and to amplify your energy as you have the final burst of momentum. Feel into your personal power and tune into any amplified emotions that might begin to stir up as the Full Moon approaches.
The Full Moon- Harvest
At around the 14th day of the lunar cycle, is the Full Moon, when the Sun and the Moon are on opposite sides of the earth. The entire Moon is illuminated from our perspective, creating the full, bright, round Moon, and in the same way you should be closing the circle on your projects which should now be completed.
It is a time to reap the benefits of reaching your goals and intention, and if you haven’t yet completed your goals, take time to re-evaluate and recalibrate and keep moving forward. The Full Moon is the celebration time where energy is abundant and at its fullest.
The waxing phase is now complete and we will move onto the waning moon phases which bring a new kind of energy to utilise in different ways.
The Waning Gibbous Moon- Gratitude
A few days after the Full Moon, it starts to recede to show a dark crescent. Use this time of the lunar cycle to reflect and be grateful for what you have accomplished. You will begin to tune inwards and may notice where you have to work harder or pay more attention . Re-evaluate your plans and make sure you practice good self-care to really nourish yourself physically and emotionally.
You might feel more reflective overall now, as well as have fluctuations in your energy levels which are beginning to wane like the moon itself. This may cause emotional ups and downs and bring some tension. If you still have loose ends to tie up, now is a good time to do them, and it’s also an optimal time to make sales or seal contracts. Also, don’t forget your New Moon intentions. Review them and clarify your why behind making those goals, clear out what no longer serves you and de-clutter your working space.
The Third-Quarter Moon- Release
3-4 days later the Moon is only half illuminated. It is important now as the moon continues to wane that you take time to rest and recover and to honour your emotions. Take a step back and allow things to flow and align. Practice kindness- to yourself and others- and let go of any negative habits. Also make sure you have clear boundaries about how you use your time as you will feel reduced energy levels at this phase. The need to clear and de-clutter will continue so keep analysing what is working and what is not and make space by releasing what no longer serves you.
The Waning Crescent Moon- Surrender
In the final days of the lunar cycle prior to being in the New Moon phase again it’s really the time to rest, recuperate and prepare for the coming fresh start. This time is all about chilling out and bringing a feeling of peace and harmony to your days. Energy levels will have receded, so keep this time to journal, reflect and apply any lessons you learnt over this lunar cycle. Look at how well you kept to your plans and intentions, and write about how happy you are with how things went over the previous weeks. Also be sure to acknowledge what you have achieved and prepare your mind for the New Moon and new goals and intentions setting to happen.
Being aware of the Moon phases gives you an opportunity to use the Moon’s energy so that you can optimise your projects and tasks by working with her natural flow. Basically, following the lunar cycle lets you more easily accomplish what you want, with less stress and struggle.
How to Use the Moon Phases for Your Business
The best way to use this information is by starting to track the phases and how you feel as you move through each of them. Try using the phases of the Moon, starting with the New Moon, to plan and schedule your projects and tasks and follow the flow of the axing Moon as you work so that you can be in alignment to the Moon’s energy.
You will find the free resources in the Lunar Planning Printables Packet to be really helpful with this- it includes everything you need to start tracking, planning and following the Moon for your business and your life. Download your free copy below:
Aligning your Business with the Moon
Once I started paying attention to the lunar phases and started to realise the impact the Moon has on my overall energy, concentration, creativity, and emotions, it was a game-changer for me. I now take the Moon’s power really seriously, and this has allowed me to do things from a more feminine approach that brings more flow and greater alignment to the way I go about doing my work.
To get started with aligning your business with the Moon phases, I recommend first looking at a lunar calendar for the month to see what date the moon is in each phase (there is downloadable and printable version of these in the Guide!).
Then start tracking to learn how the Moon affects you energetically and emotionally. This takes some time to first get into the habit of doing and then to actually start seeing the patterns in your life. Commit to tracking how you feel as the cycle progresses for 3 months. In the My Unstoppable Life Daily Journal there is a Moon energy and mood tracking wheel which makes tracking very easy to do.
Once you have enough information to reflect on and to analyse, look back through your notes and look for similarities. If you can find these patterns and themes, you can start to make small changes to the way you go about doing things. You may find that things work differently to the way I have shared here and that is ok!
With this awareness of how the Moon cycle affects you and your work, you can begin to set your goals and intention according to the energy in each moon phase.
That said, even though the Moon is predictable, life is not. That’s why it is a good idea to begin tracking as part of your daily routine so you can learn how the power of the Moon affects you individually. The whole process is about greater efficiency, less stress and more flow and alignment.
If working with the moon and the natural cycles and rhythms is something you want to explore further, I invite you to join my Moon Membership, where we have online New Moon and Full Moon retreats every month as well as focus on the self-care pillars that we need to nourish every day based on the Moon’s phase. You also get connect with like-minded others as you begin to integrate lunar self-care practices into your life and business.